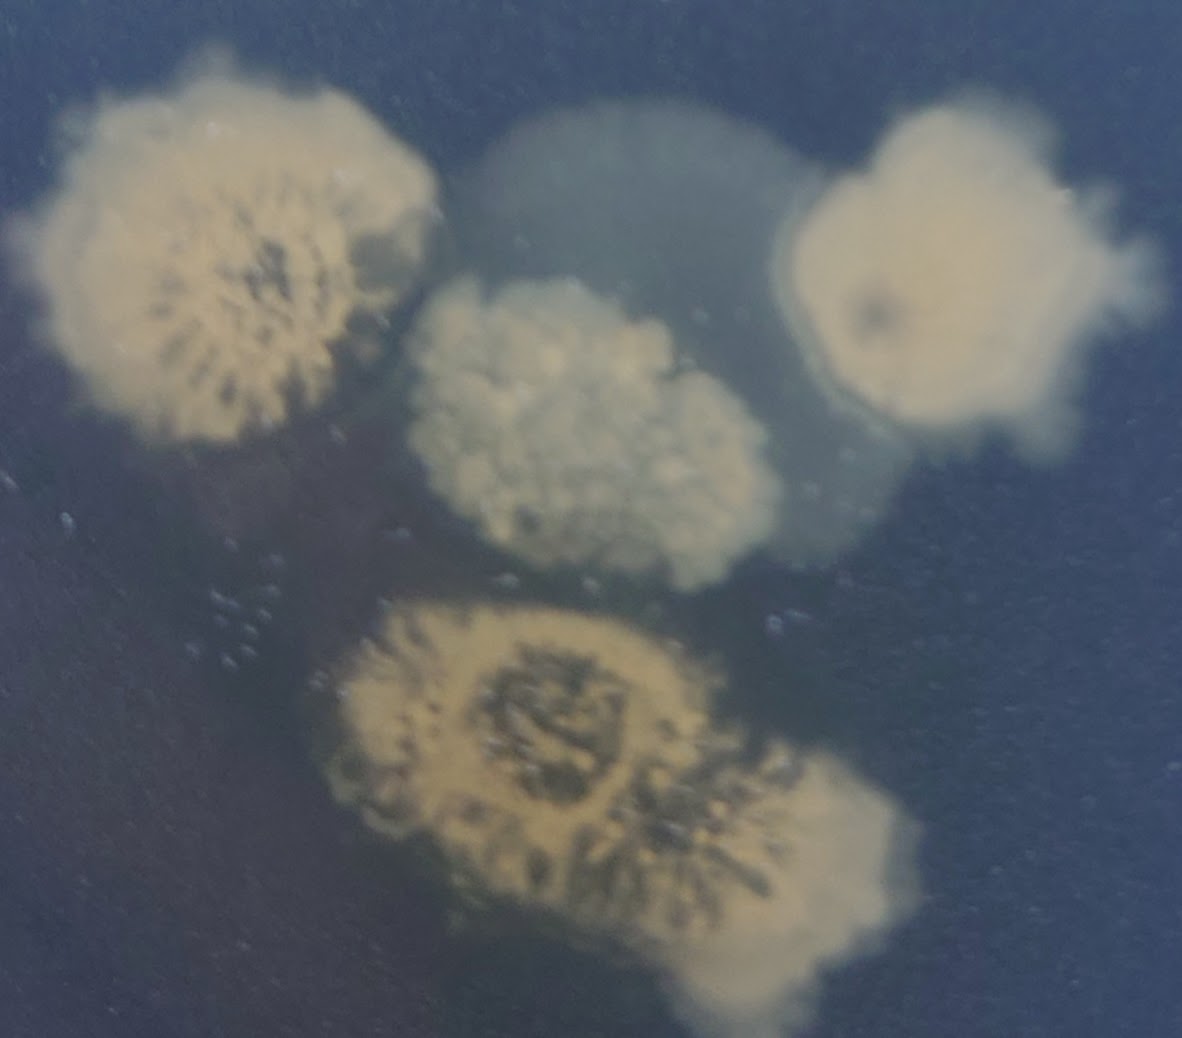

433件中 191~200件を表示
タグ『#建物のカビ検査』のページ一覧
タグ
Tags
- カビ
- 真菌検査
- カビ菌検査
- 室内検査
- カビ菌調査
- アレルギー対策
- 建物のカビ検査
- くしゃみ
- 鼻水
- 咳
- Cladosporium
- クラドスポリウム
- クロカビ
- 黒カビ
- アルテルナリア
- ススカビ
- カビ対策
- フサリウム
- アカカビ
- ピンクぬめり
- ペニシリウム
- アオカビ
- アスペルギルス
- コウジカビ
- スタキボトリス
- Stachybotrys chartarum
- オーレオバシジウム
- Aureobasidium
- Wallemia
- ワレミア
- アズキイロカビ
- 白癬菌
- トリコフィトン
- Trichophyton
- カンジダ
- Candida_albicans
- Malassezia
- マラセチア
- 常在菌
- Aspergillus fumigatus
- アスペルギルス・フミガタス
- 肺アスペルギルス症
- クリプトコックス
- Cryptococcus
- 鳩の糞
- Exophiala(エクソフィアラ)
- 黒色真菌
- Sporothrix
- スポロトリクス
- スポロトリコーシス
- Pneumocystisjirovecii
- ニューモシスチス肺炎
- PCP
- Aspergillus_oryzae
- ニホンコウジカビ
- 黄麹菌
- 黒麹菌
- Aspergillus luchuensis
- アスペルギルス・リュウキュウエンシス
- Penicillium_camemberti
- ペニシリウムカメンベルティ
- 白カビ
- Penicillium roqueforti
- ペニシリウム・ロックフォルティ
- 青カビ
- Rhizopus
- リゾープス
- クモノスカビ
- 灰色カビ
- 貴腐ワイン
- カビ検査
- Monascus
- モナスカス
- アフラトキシン
- アスペルギルス・フラバス
- Aspergillus flavus
- ユーロチウム
- 乾物トラブル
- トリコデルマ
- 椎茸栽培
- ムコール
- ケカビ
- 菌核病
- スクレロティニア
- 野菜の病害対策
- うどんこ病
- Oidium
- ガーデニング
- ケトミウム
- カビ臭対策
- 壁紙カビ
- 気管支喘息
- カビ胞子
- アレルゲン対策
- 夏型過敏性肺炎
- 自宅のカビ対策
- トリコスポロン
- 水虫
- 白癬
- アレルギー性鼻炎
- 室内環境改善
- 真菌球
- カビと健康
- 口腔カンジダ症
- 白い膜
- カンジダ対策
- アトピー性皮膚炎
- シックハウス症候群
- MVOC
- 住宅内のカビ
- 外耳道真菌症
- 食品カビ
- クローゼット収納
- 結露対策
- カーテンのカビ
- 食洗機
- 加湿器
- 健康被害予防
- 負圧
- 換気扇
- キッチン
- 2月のカビ
- 冬のカビ対策
- 湿度管理
- 結露防止
- 2月 カビ
- 冬カビ
- カビ予防
- 住まいの健康
- 節分
- 食品のカビ
- 衛生管理
- カビ臭い原因
- 部屋の酸っぱい臭い
- ニオイカビ検査
- 加湿器カビ対策
- 微生物検査
- 室内環境管理
- エアコン暖房
- 室内空気環境
- 室内カビ
- 咳・鼻炎の原因
- 住環境トラブル
- 内見 カビ チェック
- 中古住宅 カビ
- 賃貸 退去 トラブル
- 黒カビ再発
- カビ取り剤が効かない
- 壁紙カビ対策
- 押し入れカビ
- クローゼット湿気
- 収納カビ対策
- 寝具カビ対策
- マットレス湿気
- 寝室の空気環境
- 浴室黒カビ
- ゴムパッキンカビ
- カビ再発防止
- チョコレート
- 食品衛生
- 観葉植物カビ
- 室内カビ臭
- 車内カビ臭
- エアコンカビ
- 湿気対策
- 保育園カビ対策
- 施設加湿器管理
- 結露と微生物
- 水漏れカビ
- 漏水乾燥
- カビ取り
- 引っ越し前チェック
- 春の湿気対策
- 室内空気質
- 大阪
- 神奈川
- 愛知
- (IAQ)
- 埼玉
- 空気質
- IAQ
- 千葉
- 兵庫県
- 北海道
- 冬の洗濯物
- 部屋干し対策
- 室内湿度管理
- 生乾き臭
- ダウンジャケット
- クリーニング前
- 収納方法
- スキーウェア
- 保管方法
- 湿気管理
- オフシーズン
- 雨どい詰まり
- 雪害対策
- カビ原因
- 外壁カビ
- 融雪装置
- 室内環境
- 引越し準備
- 物件チェック
- 内見ポイント
- 春一番
- 換気方法
- 福岡県
- 微生物対策
- 静岡県
- 室内環境検査
- 茨城県
- 室内真菌検査
- 二重窓
- カビ防止
- 内窓
- 室内湿度
- ペアガラス
- 結露原因
- 窓結露
- 冬物布団
- 布団収納
- 押し入れ湿気
- 除湿対策
- ウォークインクローゼット
- 冬のカビ
- 収納湿気
- 受験部屋
- カビ掃除
- 部屋リセット
- 広島県カビ対策
- 京都
- 宮城県
- 新潟県
- 長野県
- 岐阜県
- 群馬県
- 浴室カビ
- 冬の湿気対策
- 換気不足
- 健康被害
- ひな祭り
- ひな人形保管
- 防カビ
- 3月カビ
- 気温差対策
- 春の湿気
- 卒業式準備
- クローゼットカビ
- フォーマル服保管
- 春の気温差
- 物件選び
- 内見チェック
- 春の雨
- 三寒四温
- ホワイトデー
- 食品保存
- 春の管理
- 一人暮らし
- 学生生活
- 部屋のカビ
- 新築マンション
- 内覧チェック
- 花粉対策
- 中古住宅
- 住宅購入
- 栃木県
- 岡山県
- 福島県
- 三重県
- 湿気・結露
- 熊本県
- 賃貸カビ
- 退去立会い
- カビ責任
- 原状回復
- カビ跡
- 賃貸トラブル
- 退去チェック
- 鹿児島県
- 沖縄県
- 滋賀県
- 愛媛県
- 長崎県
- 奈良県
- 大分県
- 岩手県
- 石川県
- 宮崎県
- 山形県
- 富山県
- カビトラブル
- 敷金返還
- 退去トラブル
- 香川県
- 秋田県
- 和歌山県
- 山梨県
- 佐賀県
- 福井県
- 観光
- 暮らしと衛生
- 徳島県
- 高知県
- 鳥取県
- 島根県
- VOC
- ホルムアルデヒド
- アレルギー
- シックハウス
- 春休み
- 旅行準備
- 留守対策
- 卒業アルバム
- 写真保管
- 長期保存
- 就職スーツ
- 衣類保管
- 新社会人
- 部屋環境
- 引越し
- 新生活
- 転勤
- 社宅
- 住環境
- 彼岸
- 墓参り
- 仏壇
- 冬物コート
- クリーニング
- 春分の日
- 大掃除
- 書類整理
- 年度末
- 紙資料
- 春のトラブル
- 健康リスク
- 新入学準備
- 教科書管理
- 湿度対策
- 段ボール管理
- 新居チェック
- 入居前準備
- 住環境改善
- オフィス移転
- 空気環境
- 新築カビ
- 引渡しチェック
- 引っ越し
- 健康管理
- 社員寮
- 新入社員
- 学生寮
- 新生活準備
- 制服保管
- 入学式準備
- 衣類ケア
- 微生物検査
- 施工不良
- 第三者カビ調査
- 雨漏り
- 水漏れ後のカビ
- 菌検査
- 掃除方法
- 家事初心者
- 気温上昇
- 除湿
- 春対策
- 試運転
- 換気扇掃除
- 春掃除
- キッチン掃除
- 春の長雨
- 4月
- 花粉症対策
- 入居後トラブル
- 住宅管理
- リフォーム
- 住宅改善
- 衣替え
- 春物衣類
- クローゼット整理
- 収納術
- 圧縮袋
- 冬物収納
- 衣類管理
- ゴールデンウィーク準備
- GW旅行
- 空き家管理
- 実家対策
- 連休準備
- 除湿方法
- 春の注意点
- 雨どい掃除
- 外壁メンテナンス
- 研修施設
- 4月の注意点
- 春のカビ
- 連休注意
- 寝具管理
- 春夏対策
- 布団ケア
- こたつ収納
- 春の準備
- カーペット管理
- 季節替え
- 扇風機掃除
- 季節準備
- 家電メンテナンス
- 除湿機
- 春の対策
- 住宅問題
- 空気環境測定
- 中古住宅カビ
- インスペクション
- 健康住宅
- カビ臭
- リフォーム注意点
- 壁紙張替え
- 高気密マンション
- 24時間換気
- 新築住宅トラブル
- 定期点検
- 壁紙剥がれ
- 脱衣所トラブル
- 雨漏りカビ
- すが漏り
- 天井裏カビ
- ゴールデンウィーク
- 留守中の家
- エアコン
- 空気環境検査
- 室内カビリスク
- 原状回復トラブル
- 賃貸管理
- ペット健康
- 室内環境
- 除菌の限界
- 専門調査
- 梅雨準備
- エアコン掃除
- GW準備
- 健康対策
- 換気計画
- 浮遊菌対策
- 院内感染対策
- 空気環境管理
- 真菌
- カビの種類
- 梅雨対策
- 実家管理
- 空き家問題
- 素材別清掃
- アルコール除菌
- 子供の健康
- アレルギー予防
- オフィス衛生
- 浮遊菌検査
- CFU検査
- 結露
- 住宅チェック
- 長期不在
- GW対策
- 帰省対策
- 連休対策
- 消臭方法
- 母の日ギフト
- 押し花
- 手作りプレゼント
- 五月人形
- こどもの日
- 掃除
- 夏型結露
- 逆転結露
- 壁のカビ
- カビ健康被害
- 天井カビ
- 病院解体
- 微生物
- 部屋干し
- 5月の湿気
- 修学旅行
- 留守中
- 運動会
- 靴保管
- 靴箱
- クローゼット
- 布団カビ
- 天日干し
- 布団乾燥
- 押入れ整理
- 除湿剤
- 衣類収納
- 梅雨前掃除
- 防カビ対策
- 浴室掃除
- 洗濯機掃除
- 洗濯槽洗浄
- エルニーニョ現象
- 線状降水帯
- 海水温上昇
- 積乱雲
- ゲリラ豪雨
- 夏の湿気
- 換気習慣
- フィルター掃除
- 観葉植物
- 水やり
- ベランダ掃除
- 排水溝掃除
- 詰まり対策
- 住宅メンテナンス
- 外壁補修
- 雨漏り対策
- ひび割れ
- 屋根点検
- 窓掃除
- パッキン劣化
- サッシ掃除
- 水抜き穴
- 窓カビ
- 黒カビ予防
- 靴箱カビ
- 靴収納
- 沖縄カビ
- エアコン臭い
- お掃除ロボット
- 高級食パン
- スマホ
- スマートフォン
- サウナハット
- サウナブーム
- しいたけ栽培
- 青カビ対策
- 給気口フィルター
- 漏水トラブル
- 家具の白カビ
- カビ臭い家
- 家にいると咳が出る
- オーディオカビ
- スピーカーメンテナンス
- 梅雨カビ
- 梅雨入り
- 梅雨換気
- 洗濯方法
- 電気代
- 除湿運転
- 冷房運転
- 衣類乾燥機
- 洗濯環境
- 赤カビ
- ロドトルラ
- 浴室乾燥機
- 電気代節約
- 靴のカビ
- 靴乾燥
- 下駄箱管理
- 新聞紙除湿
- 革靴カビ
- 革靴手入れ
- 黄カビ
- ツチアオカビ
- 木材腐朽
- 黒色酵母
- 浴室カビ対策
- スニーカーカビ
- 靴洗濯
- 下駄箱カビ
- 下駄箱臭い
- 玄関掃除
- 湿度計
- 温湿度計
- 収納環境
- 押入れカビ
- すのこ
- タンスカビ
- 壁カビ
- マットレスカビ
- ベッドカビ
- 布団乾燥機
- カビ基準値
- カビ臭い
- I_O比
- 落下菌検査
- カビ再発
- 第三者評価
- ビフォーアフター検査
- 真菌測定
- カビ調査
- 賃貸退去
- カビ見積り
- 咳の原因
- アスペルギルスフミガタス
- カビアレルギー
- 寝室環境